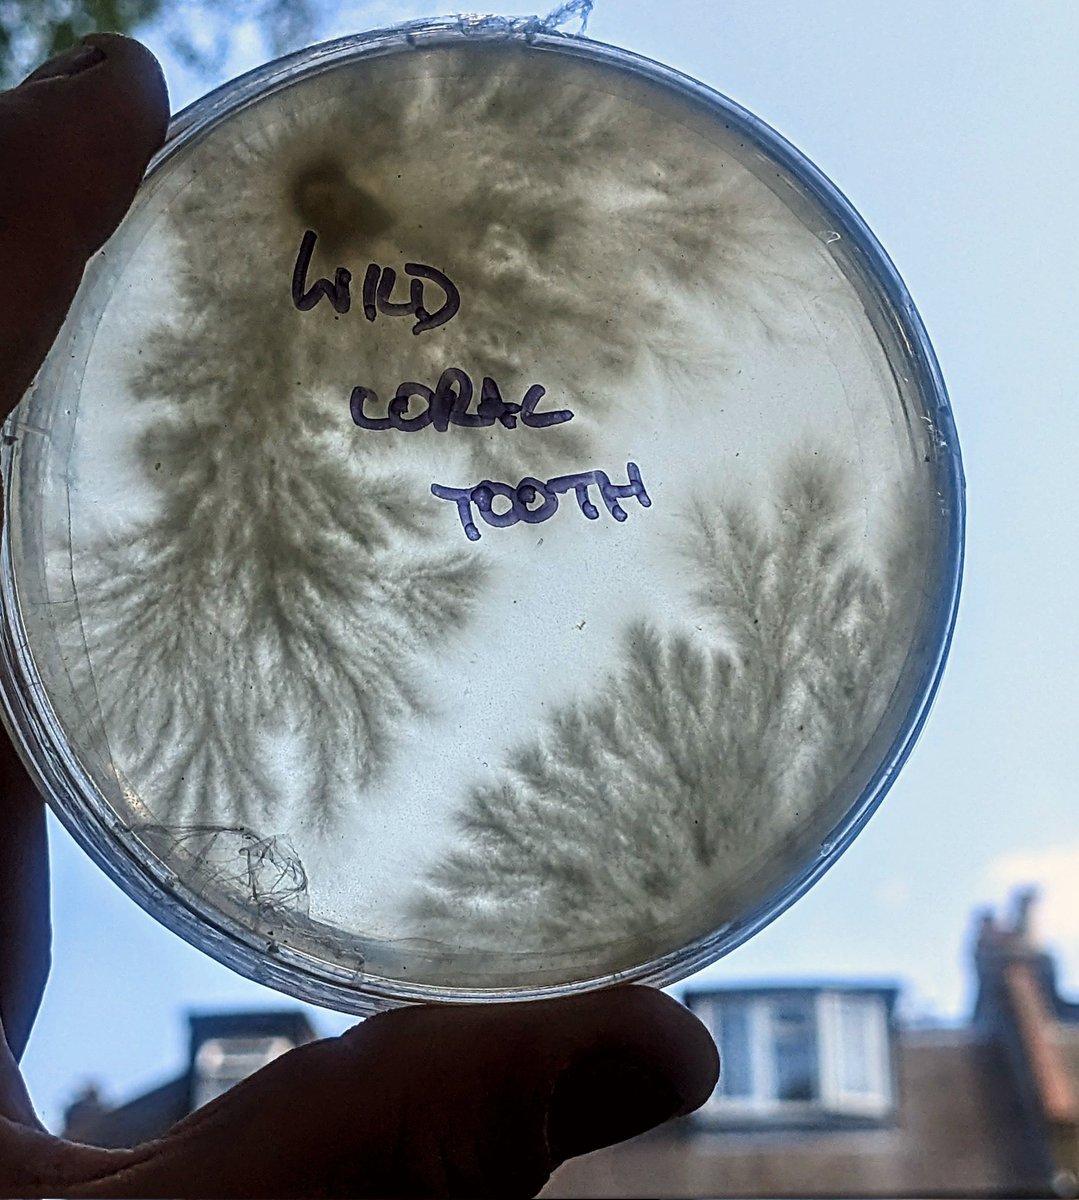
Happy #MushroomMonday

The Lockdown Garden
@gardenlockdown
Mushroom kit maker.
ID: 1304621753122066433
https://thelockdowngarden.com/ 12-09-2020 03:24:17
2,2K Tweet
1,1K Followers
782 Following


New study assessing the relationship between psychedelics and creative insight, coming out of our lab UC San Francisco. Check it out via the link below! ucsf.co1.qualtrics.com/jfe/form/SV_9s… #psychedelics #creativity







I made a big block of the wild coral tooth fungus cloned from Ladywell Fields to see how it fared in Adi Staempfli 's fruiting chamber. Thought I would share how it's been getting on for #FungiFriday (It's available to buy from Adi's Urban Mushrooms at Catford Market on Sunday)